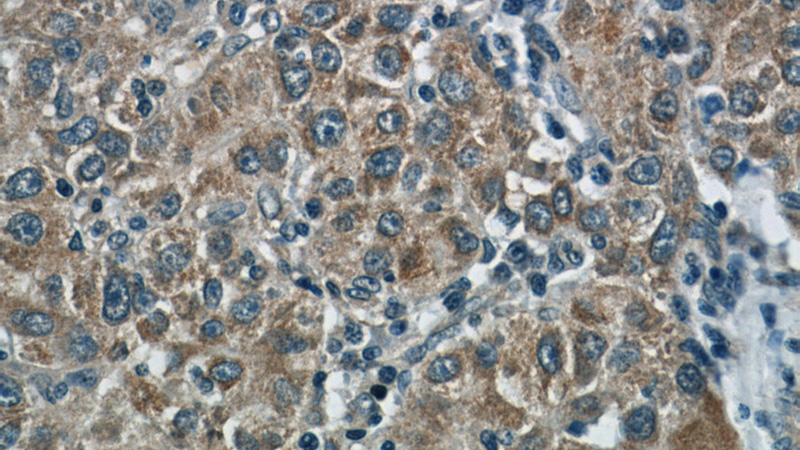
Immunohistochemistry of paraffin-embedded human liver cancer slide using Catalog No:111081(GLUL Antibody) at dilution of 1:50

-
Product Name
Glutamine synthetase antibody
- Documents
-
Description
Glutamine synthetase Rabbit Polyclonal antibody. Positive WB detected in mouse brain tissue, mouse liver tissue, rat liver tissue. Positive IHC detected in human liver cancer tissue. Positive FC detected in HepG2 cells. Observed molecular weight by Western-blot: 44kd
-
Tested applications
ELISA, WB, IHC, FC
-
Species reactivity
Human, Mouse, Rat; other species not tested.
-
Alternative names
GLNS antibody; GLUL antibody; Glutamate ammonia ligase antibody; Glutamate decarboxylase antibody; Glutamine synthetase antibody; PIG43 antibody; PIG59 antibody
-
Isotype
Rabbit IgG
-
Preparation
This antibody was obtained by immunization of Glutamine synthetase recombinant protein (Accession Number: NM_002065). Purification method: Antigen affinity purified.
-
Clonality
Polyclonal
-
Formulation
PBS with 0.1% sodium azide and 50% glycerol pH 7.3.
-
Storage instructions
Store at -20℃. DO NOT ALIQUOT
-
Applications
Recommended Dilution:
WB: 1:200-1:1000
IHC: 1:20-1:200
-
Validations

mouse brain tissue were subjected to SDS PAGE followed by western blot with Catalog No:111081(GLUL antibody) at dilution of 1:100

Immunohistochemistry of paraffin-embedded human liver cancer slide using Catalog No:111081(GLUL Antibody) at dilution of 1:50
Immunohistochemistry of paraffin-embedded human liver cancer slide using Catalog No:111081(GLUL Antibody) at dilution of 1:50

1X10^6 HepG2 cells were stained with 0.2ug Glutamine synthetase antibody (Catalog No:111081, red) and control antibody (blue). Fixed with 90% MeOH blocked with 3% BSA (30 min). Alexa Fluor 488-congugated AffiniPure Goat Anti-Rabbit IgG(H+L) with dilution 1:1000.
-
Background
GLUL(Glutamine synthetase) is also named as GS,GLNS and belongs to the glutamine synthetase family.This enzyme has 2 functions: it catalyzes the production of glutamine and 4-aminobutanoate (gamma-aminobutyric acid, GABA), the latter in a pyridoxal phosphate-independent manner By similarity. Essential for proliferation of fetal skin fibroblasts(PMID:18662667).Defects in GLUL are the cause of congenital systemic glutamine deficiency (CSGD).Organismal glutamine production is augmented secondary to an increase in the activity of glutamine synthetase in the lung and skeletal muscle(PMID:7630137). There are other bands with higher (66 kDa, 97 kDa) and lower (30 kDa)molecular weights also detected besides the 42 kDa band indicating the proteolysis of GLUL protein by the ubiquitin system(PMID:10091759).
-
References
- López-Terrada D, Gunaratne PH, Adesina AM. Histologic subtypes of hepatoblastoma are characterized by differential canonical Wnt and Notch pathway activation in DLK+ precursors. Human pathology. 40(6):783-94. 2009.
- Herbert MK, Kuiperij HB, Verbeek MM. Optimisation of the quantification of glutamine synthetase and myelin basic protein in cerebrospinal fluid by a combined acidification and neutralisation protocol. Journal of immunological methods. 381(1-2):1-8. 2012.
- Liu W, Le A, Hancock C. Reprogramming of proline and glutamine metabolism contributes to the proliferative and metabolic responses regulated by oncogenic transcription factor c-MYC. Proceedings of the National Academy of Sciences of the United States of America. 109(23):8983-8. 2012.
- Timmer NM, Metaxas A, van der Stelt I, Kluijtmans LA, van Berckel BN, Verbeek MM. Cerebral level of vGlut1 is increased and level of glycine is decreased in TgSwDI mice. Journal of Alzheimer's disease : JAD. 39(1):89-101. 2014.
Related Products / Services
Please note: All products are "FOR RESEARCH USE ONLY AND ARE NOT INTENDED FOR DIAGNOSTIC OR THERAPEUTIC USE"
